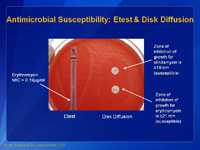
Antimicrobial Susceptibility: Etest & Disk Diffusion.

Laboratory Photo Examples
Click on the image to enlarge it.
The images below are also available in the laboratory slide set.
This is a picture of a blood agar plate. In this photo, the group A Streptococcus is in the top right portion of the agar plate; the group B Streptococcus (GBS) is shown on the top left; a group G Streptococcus is shown on the bottom right; and a group F Streptococcus is shown on the bottom left quadrant. Although the differences may not be apparent to the untrained eye, there are small differences in the size of the hemolytic activity of each of these different streptococci. GBS is the bacterium that causes the least amount of hemolytic activity, and the group F Streptococcus has the smallest colony size.

This is another picture of a blood agar plate with growth and hemolytic activity of group B streptococci (GBS) (on the left) and group A streptococci (GAS) (on the right). Note that the colonies of both bacteria appear about the same color and size, but the degree of hemolytic activity is very different. The group A Streptococcus has more hemolytic activity than the group B Streptococcus. Experienced microbiologist use these traits to identify the two types of bacteria.
Group B Streptococcus (GBS) are generally beta hemolytic on blood agar plates (right hand side). The colonies of GBS are gray to whitish-gray surrounded by a weak zone of beta hemolysis of the red blood cells in the culture medium. Non-hemolytic strains can also be encountered (left hand side) and if whitish-gray colonies are identified and suspected of being GBS, then these should be further tested.
Group B Streptococcus (GBS) isolates are catalase negative as are all other streptococci when tested with 3% hydrogen peroxide. Avoid touching loop to blood agar plate, which would cause a false-positive reaction.
Group B SStep are Gram positive cocci in pairs and short chains on Gram stain.
The most accurate way to identify group B Streptococcus (GBS) is to demonstrate that the bacteria in question has the Lancefield group B antigen on the surface of the bacteria. The Lancefield antigens are called group A, B, C, D, etc. Each of the antigens is associated with a certain kind of bacteria. In the case of GBS, the antigen we are looking for is called group B. This picture shows a slide agglutination test that is used to identify the group antigens of streptococci. The general procedure, for this test, is to make a small suspension of bacteria from the blood agar plate with a bacteriologic loop of culture and place it on the test card shown above. The suspension is placed in both circles. Group specific antibodies from a commercial grouping kit are then placed on the suspension. Next, the suspension of bacteria is mixed with the group specific antibody and tilted back and forth for about one minute. In this case, we put group B antibodies in the circle on the left and group A antibodies in the circle on the right. A positive agglutination reaction is shown on the left. Note the clumping of the suspension of bacteria. A negative reaction is shown on the right. The suspensions mixed with the group A reagent are smooth; no clumps are apparent. These results indicate we have identified a group B Streptococcus.
If the laboratory is not able to identify group B streptococci (GBS) by the Lancefield grouping procedure, there are other microbiologic tests that can be used to identify GBS. This picture shows one of these tests. It is called the CAMP test. CAMP is an acronym for the authors of this test (Christie, Atkinson, Munch, Peterson). The CAMP test takes advantage of the capacity of GBS to produce this CAMP factor; most other hemolytic streptococci do not produce CAMP factor. This picture shows the group B Streptococcus (on the right) and a group A Streptococcus (GAS) (on the left). Down the middle we have inoculated the plate with a Staphylococcus aureus strain (vertical streak). We then inoculated the GBS (on right) and GAS (on left) perpendicular to the Staphylococcus streak. We inoculated the agar plate so as not to touch the two different organisms (Staphylococcus and Streptococcus) but to come close to each other. The Staphylococcus is used because it produces a lysin that only partially lyses the red blood cells (called beta-lysin). The CAMP factor reacts with the partially lysed area of the blood agar plate to enhance the hemolytic activity. Note the arrowhead shape of the zone of enhanced hemolytic activity by the GBS near the Staphylococcus streak (on right) but not by the GAS (on left). This means that the bacterium on the right is GBS because it is producing a CAMP factor.
This test is an additional presumptive test used to aid in the identification of GBS. Hippurate (hippuric acid) is a benzene (6 carbon) ring with the amino acid serine attached to one of the carbon molecules. Hippuricase, the enzyme, cleaves the benzene ring and the serine free from each other. In this case, some of the growth on a blood agar plate is suspended in a hippurate broth and incubated for 4 hours. Next, a reagent ninhydrin is added. If a purple color develops, in the tube, the test is positive. The test detects the amino acid serine that has been cleaved from the hippuric acid. The second tube is positive for hippurate hemolysis and presumptive identification of GBS.
This is an example of beta-hemolytic group B Streptococcus (GBS) growing in StrepB carrot broth. This media is a pigmented enrichment broth and the tube on the right shows a positive color change, indicating the presence of beta-hemolytic group B strep. Selective enrichment broths that incorporate chromogenic pigments for the detection of GBS using color detection can be used as an alternative to enrichment in Lim or TransVag broth. If no color is detected in the broth then the broth should be subcultured to an appropriate agar plate and further tested, or the broth can be tested directly to determine if GBS is present.
Depicted above are two methods for determining antimicrobial susceptibility of group B Streptococcus (GBS). It is especially important that the microbiologist determine the susceptibility of GBS to clindamycin (and erythromycin since there may be inducible clindamycin resistance) as this drug is used as a substitute if the patient cannot be treated with penicillin. The long strip on the left is called the E-testTM. This picture shows the drug erythromycin (EM). In this test, the strip contains a gradation of antibiotic with the strongest being at the top of the strip and the weakest at the bottom. The minimum inhibitory concentration (MIC) of antibiotic that will inhibit the bacteria is determined by where the growth of the bacteria starts, or the area of the growth where the ellipse growth meets the strip. For this example the MIC for erythromycin is 0.19 µg/ml which is considered to be susceptible based on CLSI breakpoints. Consult the latest CLSI manual* for interpretation of MICs for Streptococcus spp. Beta-hemolytic Group (2015 breakpoints): Clindamycin: ≤0.25 μg/ml = susceptible, 0.5 μg/ml = intermediate, and ≥1.0 μg/ml = resistant; and for Erythromycin: ≤0.25 μg/ml = susceptible, 0.5 μg/ml = intermediate, and ≥1.0 μg/ml = resistant. The two disks on the right of the agar plate are erythromycin (E) and clindamycin (DA). There are criteria for the zones of inhibition of growth that determine whether or not the bacteria are susceptible or resistant. In the test shown above, the bacterium is susceptible to erythromycin (the zone is ≥21 mm) and susceptible to clindamycin (zone is ≥19 mm). The disk test is perfectly satisfactory for determining the antimicrobial susceptibility of GBS. Interpret according to CLSI guidelines for Streptococcus spp. Beta-hemolytic Group (2015 breakpoints for disk-diffusion: for clindamycin: ≥19 mm = susceptible, 16–18 mm = intermediate, and ≤15 mm = resistant; for erythromycin: ≥21 mm = susceptible, 16–20 mm = intermediate, and ≤15 = resistant.
*Clinical and Laboratory Standards Institute. Performance standard for antimicrobial susceptibility testing, M100-S20 (2010), M-2 and M-7, Wayne, PA.
This slide shows a broth microdilution antimicrobial susceptibility test. This method is the most accurate method of determining the antimicrobial susceptibility of GBS. This microtiter plate has 96 wells, with 8 rows of wells, labeled A through H. Each row of wells contains one antibiotic. In each row there are 12 wells. Each well contains a different concentration of the specific antibiotic, usually doubling dilutions. In this case, Row A contains clindamycin starting at the left at ≤0.015 µg/ml and increasing in doubling dilution to 32µg/ml in well 12. The minimum inhibitory concentration (MIC) is >32µg/ml for clindamycin which is considered resistant for GBS. In row F, we have penicillin in wells 1 through 8 with a beginning concentration of ≤0.008µg/ml and a final concentration of 1µg/ml. The MIC for this isolate to penicillin is 0.06µg/ml which is considered susceptible. Row G, contains erythromycin in wells 1 through 11, with concentrations ranging from ≤0.03µg/ml to 32µg/ml. The MIC for this isolate to erythromycin is 8µg/ml which is considered resistant. Since this is a standardized test, results can be compared world-wide if the standard procedures are used. Consult the latest CLSI manual for interpretation of MICs for broth microdilution for Streptococcus spp. Beta-hemolytic Group (2015 breakpoints). Clinical and Laboratory Standards Institute. Performance standard for antimicrobial susceptibility testing, M100-S26 (2015), M-2 and M-7, Wayne, PA.
To ensure accurate results for susceptibility testing of group B Streptococcus (GBS) laboratories should include a test for detection of inducible clindamycin resistance. The double-disk diffusion method (D-zone test) is recommended for testing erythromycin-resistant and clindamycin-susceptible GBS that are from penicillin-allergic women at high risk for anaphylaxis. Other validated tests to detect inducible clindamycin resistance in GBS may be used in place of the D-zone test. Note that the erythromycin (15 µg) disk and a clindamycin (2 µg) should be 12 mm apart (this is different from recommended 15-26 mm for staphylococci and a disk dispenser cannot be used to place disks on the plate for streptococci testing). This slide shows a positive D-zone test for GBS. This isolate has a blunting of the inhibition zone around the clindamycin (CC) disk adjacent to the erythromycin disk (E) (indicated by arrow) and shows a characteristic D-shape. This test for D-zone indicates that this isolate is positive and should be considered to have inducible clindamycin resistance and is presumed to be resistant.
The following comment could be included in patient reports for isolates that show inducible clindamycin resistance: "This isolate is presumed to be resistant on the basis of detection of inducible clindamycin resistance. Clindamycin still might be effective clinically in some cases."
- Page last reviewed: May 23, 2016
- Page last updated: May 23, 2016
- Content source:




 ShareCompartir
ShareCompartir